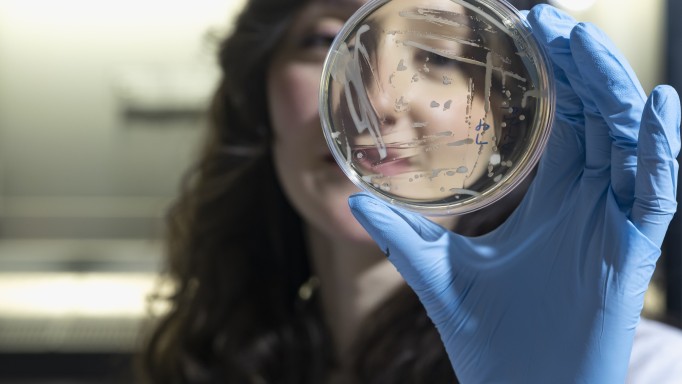

SCROLLEN & BLÄTTERN
Stories of Innovation
Forschung und Entwicklung und nackte Fakten? Auch. Vor allem aber: Menschen und starke Stories.
Wir konnten keine Ergebnisse finden. Bitte passe deine Filtereinstellungen/ Suchanfrage an und versuche es erneut.

3 MIN WATCH
Mit KI gegen Parkplatzstress
04.05.2026

3 MIN WATCH
Hightech im Apfelbaum
29.04.2026

3 MIN WATCH
Wenn Berge Daten zeigen
24.04.2026

6 MIN READ
Daten für eine blühende Zukunft
21.04.2026
2 MIN WATCH
Fermentation: Altes Wissen neu gedacht
20.04.2026

2 MIN WATCH
Bikebox, Bus und Bahn
25.03.2026

2 MIN WATCH
Barrierefrei auf die Skipiste
19.12.2025

3 MIN WATCH
Automatisierung mit Fingerspitzengefühl
12.12.2025

4 MIN WATCH
Die Mensa der Zukunft
08.12.2025

2 MIN WATCH
Smarte Daten, smarter Tourismus
24.11.2025

3 MIN WATCH
Radikale Innovation für grünere Städte
29.10.2025

3 MIN WATCH
Am Puls(e) der Zeit
23.10.2025

2 MIN WATCH
Sauce mit Kultstatus
26.06.2025

2 MIN WATCH
Training mit Augmented Reality
17.04.2025

2 MIN WATCH
CAEmate revolutioniert die Überwachung von Infrastrukturen
17.03.2025

2 MIN READ
Fruchtgummis vom Bauernhof
17.12.2024

2 MIN WATCH
MaaS: Daten beschleunigen die Mobilität
21.11.2024

3 MIN WATCH
Meran: Schneller einen Parkplatz finden mit Open Data Hub
21.11.2024

2 MIN WATCH
TREPHOR @ Kitchen Lab
10.10.2024

2 MIN WATCH
Kitchen Lab meets Korea
28.08.2024

2 MIN WATCH
Für die Fische…
07.08.2024

1 MIN WATCH
„Urban Shield“ – Stadterneuerung zwischen Kunst und Innovation
01.08.2024

3 MIN READ
Kleine Luftfahrzeuge ganz groß
06.06.2024

2 MIN READ
„Mit Butz und Stingl“: Neues Leben für Nebenprodukte von Apfel und Co.
03.06.2024

3 MIN READ
Intelligente Technologien für nachhaltige Gebäude
27.05.2024

3 MIN READ
Loacker auf dem Weg zur Smart Factory
15.05.2024

3 MIN READ
Wenn Heizung, Lüftung und Beschattung zusammenarbeiten
14.05.2024

3 MIN WATCH
Herzstillstand am Berg: Drohnen als Lebensretter
10.05.2024

3 MIN READ
Wenn Bäume sprechen lernen
08.05.2024

4 MIN READ
Ein Jahr NOI Techpark Bruneck: im Gespräch mit Klaus Mutschlechner
06.05.2024

3 MIN READ
Klimaresiliente Landwirtschaft
03.05.2024

3 MIN READ
Roboter helfen beim Recycling
23.04.2024

2 MIN READ
Daten als Nachhaltigkeitstreibstoff
19.04.2024

4 MIN READ
Mehr Photovoltaik, innovativeres Stromnetz
03.04.2024

5 MIN READ
NATURALSALUS – Vom Start-up zum Business Angel
07.02.2024

2 MIN WATCH
Backfrische Pizza vom Roboter
25.01.2024

4 MIN READ
Essensreste nachhaltig verwerten
17.01.2024

6 MIN READ
Qualitätssiegel für Produkte
13.12.2023

3 MIN WATCH
Vom Regen in die Traufe? Nicht mehr!
13.12.2023

2 MIN WATCH
Steine Zählen, Überschwemmungen vorbeugen
09.12.2023

3 MIN READ
„Unkonventionelle“ Start-ups: die neue Ära
28.11.2023

1 MIN READ
Langes Leben für E-Bikes und Smartphones
23.11.2023

5 MIN WATCH
Kampfansage an den Klimawandel – mit kostengünstigen Sensoren und künstlicher Intelligenz
04.10.2023

3 MIN READ
Landwirtschaftsroboter, made in Südtirol
01.09.2023

2 MIN WATCH
Alvus und das Beispiel der Bienen
17.08.2023

3 MIN WATCH
Fortissimo, bei Musik geht es um Innovation
21.07.2023

4 MIN WATCH
Garum Project, der Schmetterlingseffekt der Fermentation
18.07.2023

5 MIN READ
Booster für Qualitätsprodukte
29.06.2023

5 MIN READ
Food & Health: die Zukunft unserer Lebensmittel führt uns in die Vergangenheit
20.06.2023

3 MIN READ
Energieeffizienz neu berechnet
23.05.2023

5 MIN READ
Sedimente smart steuern
23.05.2023

5 MIN READ
Südtiroler Automotive-Firmen als Vorreiter bei CO₂-Fußabdruck
11.04.2023

4 MIN READ
Nachhaltig, sozial und flexibel: Coworking im neuen NOI Techpark Bruneck
07.04.2023

5 MIN WATCH
CPE: Von der One-Man-Show zum interdisziplinären Forschungsteam
01.04.2023

5 MIN WATCH
Einmal gemischten Salat bitte, frisch gefischt!
01.04.2023

3 MIN WATCH
Hochwasserschutz aus dem Labor
22.03.2023

3 MIN READ
Innovativer Tourismus durch Daten
11.03.2023

3 MIN WATCH
Die intelligente Kraft des Lichts
01.02.2023

3 MIN READ
Im Windkanal
24.01.2023

3 MIN WATCH
Abkühlung aus dem Fluss
16.11.2022

3 MIN READ
Simulationen: wie eine Intuition die Produktentwicklung nachhaltig verändert
15.09.2022

3 MIN WATCH
AUTOMATISCH, PRAKTISCH, GUT
14.09.2022

2 MIN WATCH
Kühlen mit Gletscherwasser
14.09.2022

3 MIN WATCH
Landwirt-schaf(f)t dank Technologie
14.09.2022

2 MIN WATCH
Receptic: der Werkzeug-Tracker
14.09.2022

MIN WATCH
Wenn Sensoren beim Laufen helfen
14.09.2022

3 MIN WATCH
Vermessung der Welt
22.08.2022

2 MIN WATCH
SINCRO, intelligente Sensoren für nachhaltigere Gebäude
20.07.2022

4 MIN READ
Neues Leben für Apfelkerne
01.04.2022

3 MIN WATCH
Licht für indische Nächte
08.11.2021

3 MIN READ
Die Hightech-Anlage zur Biomassevergasung
19.10.2021

3 MIN READ
High-Tech am Berg: Wie Drohnen Südtirols alpines Know-how potenzieren
27.07.2021

3 MIN READ
Die Energie, die aus Schlamm kommt
08.07.2021

4 MIN READ
Mit Ozon gewaschene Äpfel
30.06.2021

3 MIN READ
Lernen von der Natur
21.06.2021

2 MIN WATCH
Beton neu gedacht
17.05.2021

3 MIN READ
Sarner Erfindergeist: Wie ein Kunstschmied zum High-Tech-Unternehmer wurde
12.04.2021

3 MIN WATCH
Lasten fliegen lassen
18.02.2021

2 MIN WATCH
Wachsen mit Rückenwind
18.02.2021




